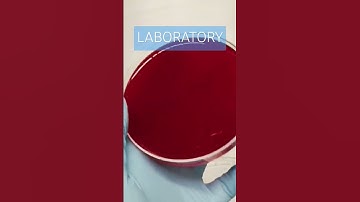
Life inside the Laboratory #medtechlife #laboratorylife #themedtechlab

⬇ DOWNLOAD NOW
Kalau muncul iklan pop-up, tutup lalu klik tombol kembali
Download lagu Working with urine inside the Laboratory #medtechlife #laboratorylife #medtechstudent #cls #mls #rmt secara gratis hanya untuk keperluan promosi. Dukung artis favorit kamu dengan membeli musik original di iTunes atau platform resmi lainnya.
 life inside the Laboratory #cls #medtechstudent #medtech #medtechlife #laboratorylife
life inside the Laboratory #cls #medtechstudent #medtech #medtechlife #laboratorylife
 inside the Laboratory #medtechlife #laboratorylife #medtechstudent #cls #mls #blood #lab
inside the Laboratory #medtechlife #laboratorylife #medtechstudent #cls #mls #blood #lab
 Life inside the Laboratory #medtechlife #laboratorylife #themedtechlab
Life inside the Laboratory #medtechlife #laboratorylife #themedtechlab
Life inside the Laboratory #medtechlife #laboratorylife #themedtechlab
Life inside the Laboratory #medtechlife #laboratorylife #themedtechlab
 Life inside the Laboratory #medtechlife #laboratorylife #medtechstudent #medtech
Life inside the Laboratory #medtechlife #laboratorylife #medtechstudent #medtech
 medtech daily life #laboratory #medtechstudent #cls #mls #clinicallaboratory #laboratorylife #lab
medtech daily life #laboratory #medtechstudent #cls #mls #clinicallaboratory #laboratorylife #lab
 Transferring urine in a tube #laboratory #medtechstudent #cls #mls #urine
Transferring urine in a tube #laboratory #medtechstudent #cls #mls #urine
 The Medtech Life #mls #cls #medtechstudent #medtech #laboratory #medicaltechnologist #laboratorylife
The Medtech Life #mls #cls #medtechstudent #medtech #laboratory #medicaltechnologist #laboratorylife